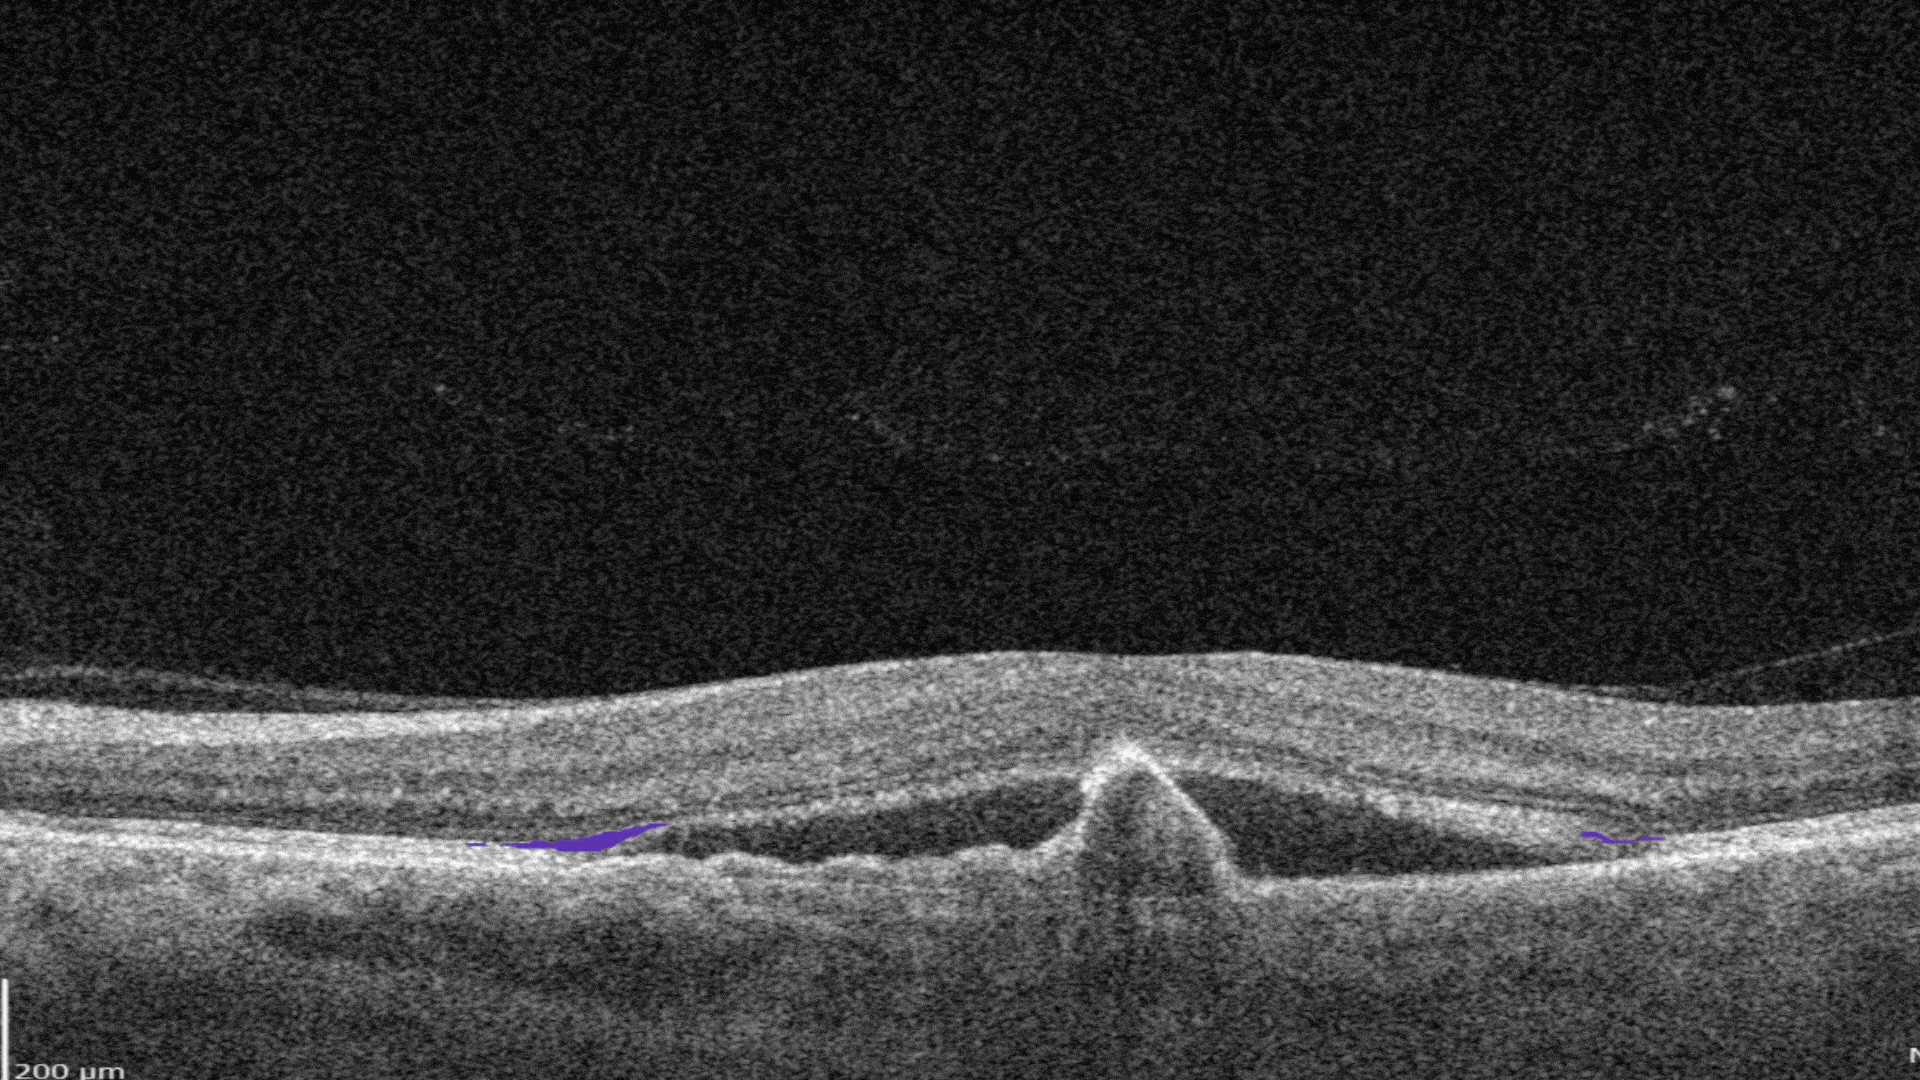
OCT Optometry: AI for OCT detection of Ellipsoid zone disruption
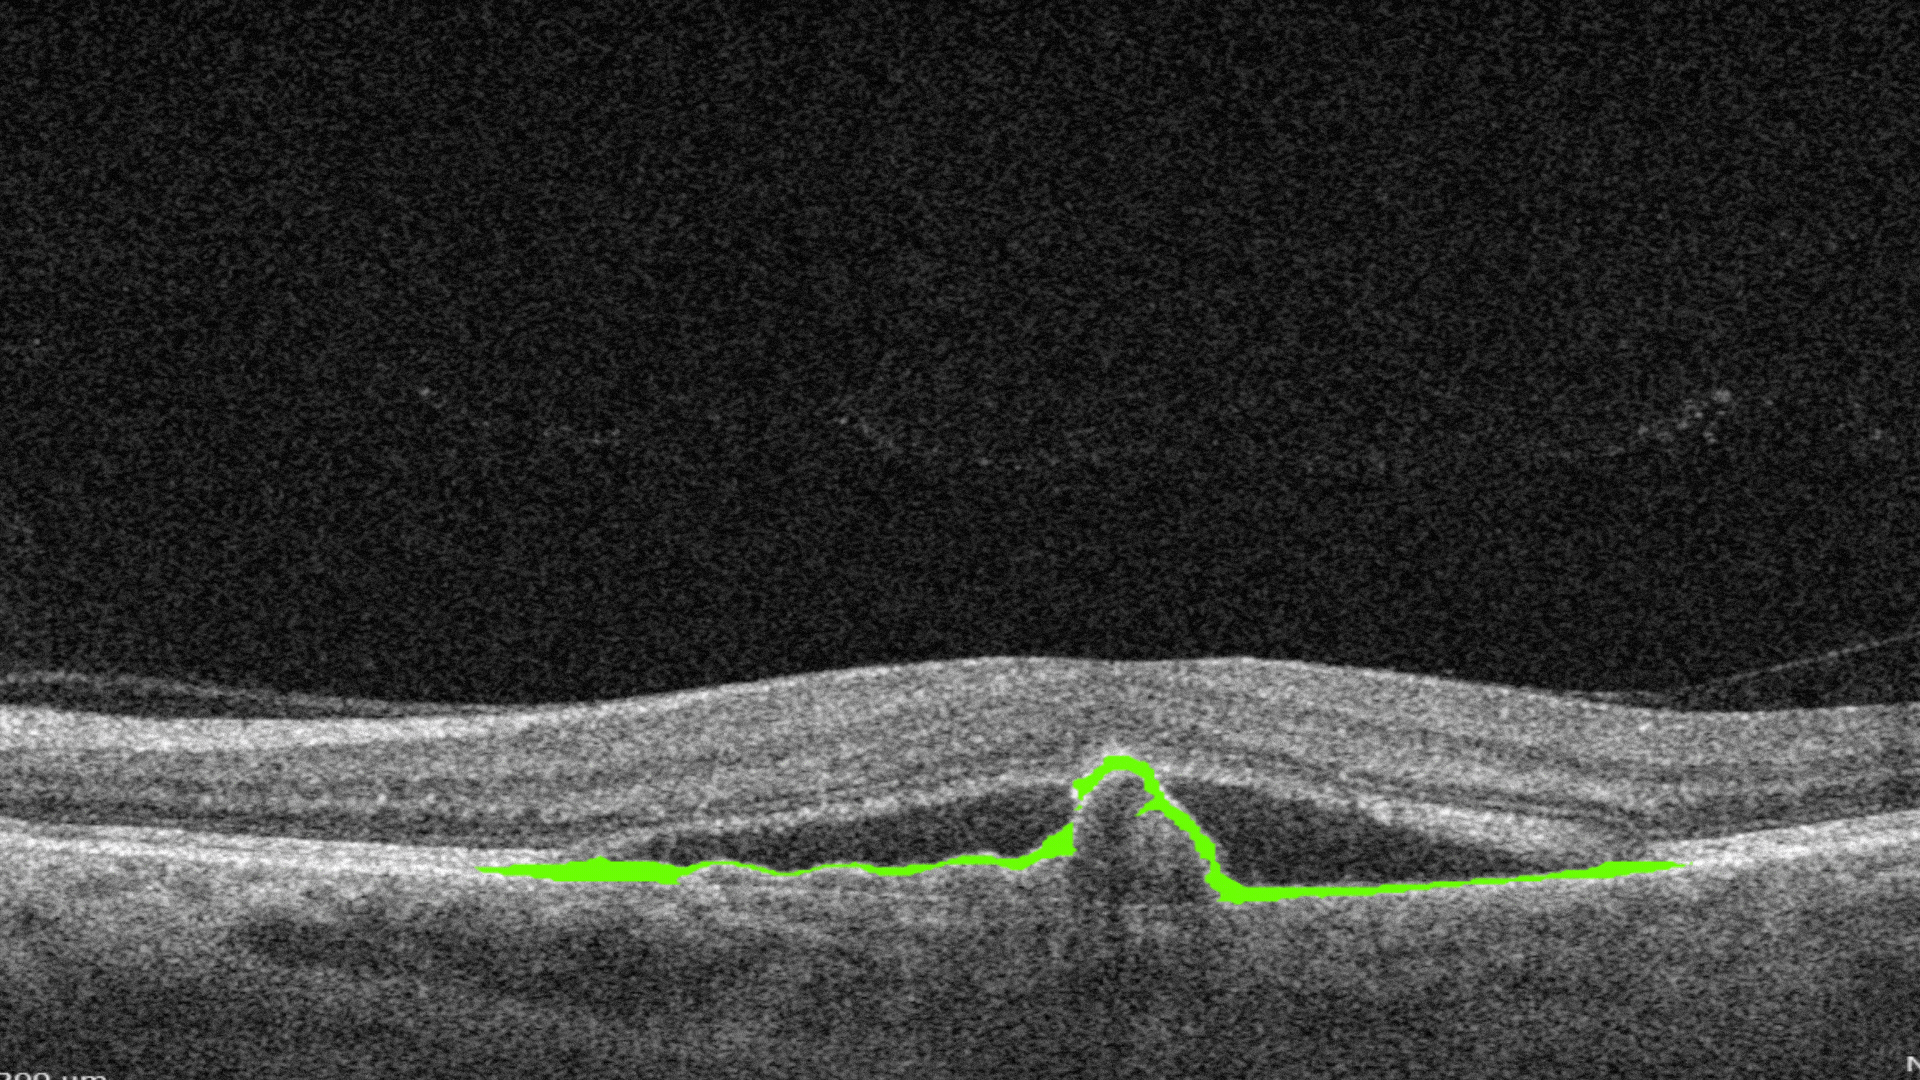
OCT Optometry: AI for OCT detection of RPE disruption
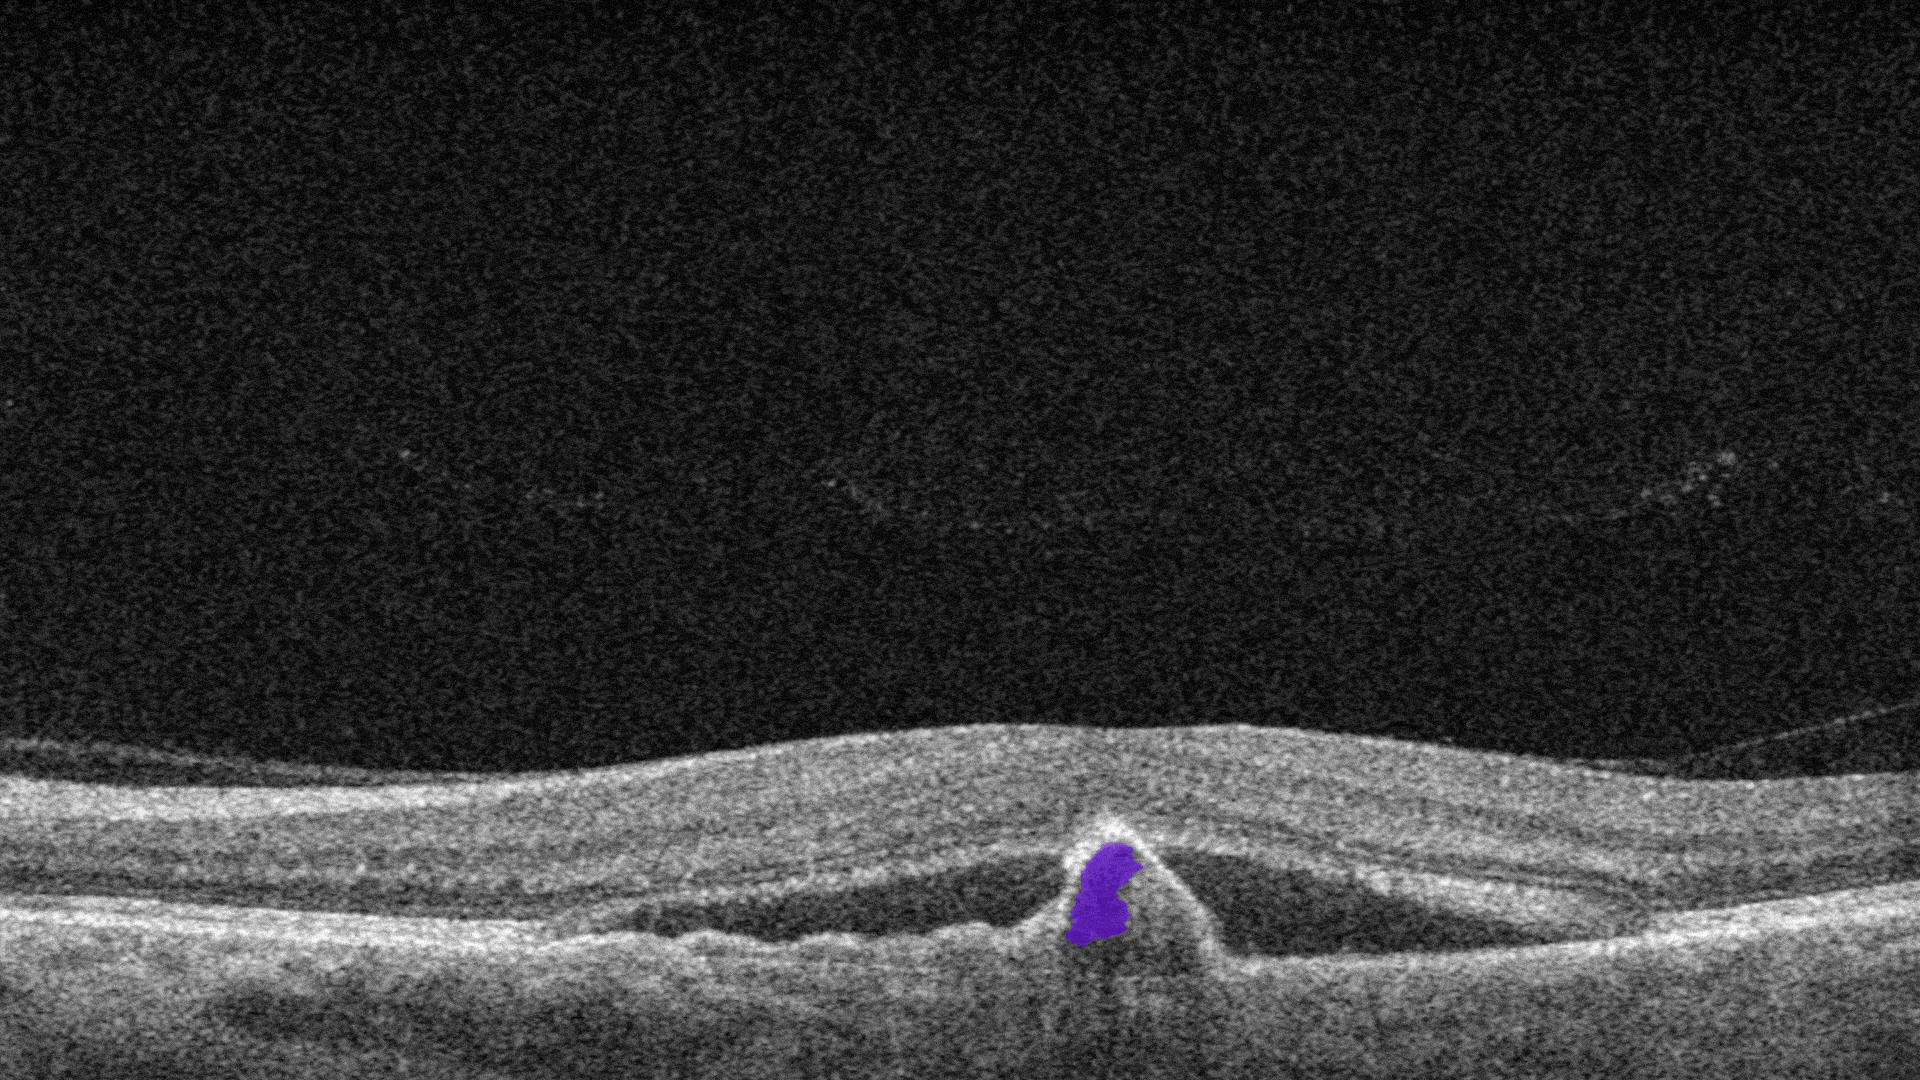
OCT Optometry: AI for OCT detection of Fibrovascular RPE detachment

AI-powered OCT workflow with Altris AI


Maria Znamenska, Retina Expert, PhD Ophthalmology, Altris AI Medical Director
AI Decision Support for OCT analysis by Altris AI is the right way to enable early detection of biomarkers and retina pathologies, such as glaucoma and monitor treatment effectively.
My name is Maria Znamenska, I am an ophthalmologist, a PhD in ophthalmology, and the Medical Director of Altris AI. I have been practicing and teaching OCT for more than 16 years. I want to show how Artificial Intelligence can be used for OCT scan analysis with real OCT scans with AMD, DR, early glaucoma, and GA.
For any modern optometry, OCT is an indispensable tool today. With AI for OCT scan analysis, optometrists improve the referral process, increase ROI on OCT, and educate patients on what is going on with their retina with the help of color coding. With AI-powered analysis of OCT, the optometry business becomes truly modern and digital.
Navigating GA, wet AMD, and DR with Altris AI Workflow
Altris AI AI for OCT Workflow for Optometrists
No time for a video? Scroll down to see a series of animated videos.
14 Days of Free Trial to everyone who is ready to try
Free Trial
Using Altris AI workflow for GA, DR, wet AMD patients.
-


After uploading B-scans into the platform, you start with the severity differentiation module to speed up the screening process for patients. All these b-scans are visualized in a severity cube and you instantly see that there are pathological scans ( marked in red), non-pathological scans ( marked in green), and scans with a medium level of pathology ( yellow). So you can work directly with pathological scans
-


The referral urgency score designed especially for optometrists suggests how soon this patient’s referral is needed.
-


Next, you explore the pathology detection module as inside it you can analyze pathological scans on the presence of 70+ retina pathologies and biomarkers. Here you see that the module detects 70 + biomarkers and supports with the diagnostic decision-making.
-


In the Measurements module, you can assess a dedicated feature for calculating the GA area. This tool automatically calculates the GA lesion by measuring the overlap between two (Hypertransmission and RPE Atrophy) or three biomarkers (adding Neurosensory Retina Atrophy).
To track a patient’s condition over time across multiple OCT exams, simply use the GA Area Progression feature within our Pathology Progression module.
-


The glaucoma module assesses if there is an early risk of glaucoma based on GCC asymmetry analysis.
-


Building on our GCC Asymmetry Analysis, the Advanced Optic Disc Analysis measures key optic disc parameters, including Disc Area, Cup Area, Cup Volume, Cup Depth, Cup/Disc Area Ratio, and Rim Absence Angle. Using these personalized calculations, the AI assigns a severity score from 1 to 10 on the Disc-Damage Likelihood Scale.
-


Customizable reports mean you can add only the information you need for a referral or create the report in such a way that it will comprehensible for patients as well.
CHOOSE A PATIENT JOURNEY
AI-powered OCT workflow for the patient with GA
Geographic atrophy (GA) is a chronic progressive degeneration of the macula, as part of late-stage age-related macular degeneration (AMD).
See how Altris AI analyzes OCT scan with GA
-


The platform allows you to analyze Geographic Atrophy (GA) using each of its biomarkers individually. You can also use a dedicated feature to calculate the total GA area and track its progression over time.
-


Hypertransmission is one of the first noticeable biomarkers of DR we clearly see with the help of Altris AI.
-


We also see hard drusen which are small, round, well-defined deposits with a diameter measuring less than 63 microns.
-


Soft drusen are also noticeable on this OCT quite obviously. Soft drusen are concentrated at the central macula and appear decreasingly towards the peripheral retina.
-


Ellipsoid zone disruption. Changes in the photoreceptor layer can be identified as a disruption or defect in the ellipsoid zone (EZ).
-


Neurosensory retina atrophy. Thinning and loss of retina layers because of retina atrophy
-


RPE disruption. Elevation of the Retinal Pigment Epithelium layer.
-


RPE atrophy. An extensive area of geographic, submacular pigment atrophy involves the entire posterior retina between the temporal retinal vascular arcades.
AI-powered OCT workflow for the patient with DR
Diabetic retinopathy (DR) is a microvascular disorder caused by vision-threatening damage to the retina, a long-term sequela of diabetes mellitus.
See how Altris AI analyzes OCT with DR
-


Hard exudates. They are composed of lipid and proteinaceous material, such as fibrinogen and albumin that leak from the impaired blood–retinal barrier.
-


Diffuse Edema. It is a thickened areas of lower reflectivity in the outer retina but specifically without cystoid spaces.
-


Intraretinal hyprereflective foci are typically dot-like or round, regular lesions seen in all the retinal layers and choroid
-


Intraretinal cystoid fluid. The fluid inside the retina which is accumulated as cystic cavities.
AI-powered OCT workflow for the patient with Wet AMD
Wet AMD is the type of AMD that develops when abnormal blood vessels grow into the macula
-


Ellipsoid zone disruption is the changes in the photoreceptor layer can be identified as a disruption or defect in the ellipsoid zone (EZ).
-


RPE Disruption is the disruption of the Retinal Pigment Epithelium layer
-


Subretinal fluid corresponds to the accumulation of a clear or lipid-rich exudate (serous fluid) in the subretinal space, i.e., between the neurosensory retina (NSR) and the underlying retinal pigment epithelium (RPE), in the absence of retinal breaks, tears, or traction
-


Fibrovascular RPE detachment. Delamination of the pigment epithelium of the retina is caused by the presence of newly formed vessels (fibrovascular membrane) under the RPE.
-


Subretinal hyperreflective material (SHRM). It’s a hyperreflective material that is external to the retina and internal to the retinal pigment epithelium (RPE)
AI-powered OCT workflow for the patient with Glaucoma
-


Early Glaucoma assessment risk is based on Ganglion Cell Complex (GCC) asymmetry analysis of the hemispheres.
-


Based on the level of asymmetry glaucoma risk is defined as low, medium or high.
-


For more detailed analysis we overlayed an 8×8 grid on the 6 by 6 macular area and asymmetry analysis compares each grid area of one hemisphere with the opposite hemisphere.
-


Advanced Optic Disc Analysis measures key optic disc parameters, including Disc Area, Cup Area, Cup Volume, Cup Depth, Cup/Disc Area Ratio, and Rim Absence Angle. Using these personalized calculations, the AI assigns a severity score from 1 to 10 on the Disc-Damage Likelihood Scale.
Reach full experience using AI for OCT Examination Analysis
Book a demo
AI-powered OCT optometry analysis is a chance for every optometrist to unleash the whole potential of this diagnostic tool.
OCT is the most effective method of retina diagnosis yet it requires years of learning and practice to truly master it. Altris AI ( AI for OCT) analysis becomes a solid and reliable diagnostic decision-making support tool for optometrists and dispensing opticians.
- Altris AI advises on the urgency of a referral
- Altris AI detects 70+ pathologies and biomarkers
- Altris AI assesses early risk of glaucoma
- Altris AI provides the chance to build customisable reports